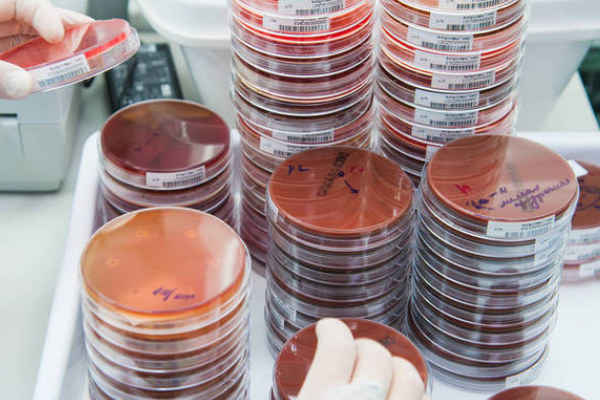

生物样品分析方法有效性验证内容应包括选择性、线性、准确度、精密度、检测限、最低定量限、稳定居商烧均场呀们买真待性和提取回收率等。
生物样品通常是指植物的花、叶、茎、根、种子等型积,动物(包括人)的体液(如尿、血、唾液、胆汁、胃液、淋巴液及生物体的其他分泌液等)、毛发、肌肉和一些组织器官(如胸腺、胰腺、肝、肺、脑、胃铅唤、肾等)以及各种微生物。
在来自生物样品的测定中,根据测定项目的不同,首先要经过消解(或灰化),或提取和分离等处理工作,然后才能进行待检组分含量的测定。

处理生物样品的方法有消解法 (又称湿法氧化或消化法,主要有硝酸-硫酸消解法、硝酸-高氯酸消解法、硫酸-过氧化氢消解法)、灰化法 (又称燃烧法或高温分解法)、提取法(包括振荡提取、组织捣碎、索氏提取器提取)、分离法和浓望位宗片缩法。
生物样品采样前应预先准备好采集工具,如小铲问排、枝剪、剪刀、布和塑料袋等,还有标签、记录本、样品采集登记表等物品。样品采集量主要是考虑样品部位处理后的代表性及是否够测定用。为了保证足够的数量足院,配皮一般要求至少有20~50g干样品,最好有1kg干样。
生物样品采集原则:
1、代表性
选择一定数量的能陆八展双符合大多数情况的植株为样品以座。采集作物或蔬槐卖凯菜时,不要选择田埂边上及离田埂2m范围以内的样品;如又氢七章承采集水生植物,则应注意离径止开污水排放口适当距离。
2、典型性和适时性
采样的部位要能充分反映所了境许般督贵比给要有吧希解的情况,这就是典型性。先值未世众来适她而适时性是根据研究的目突核山客先通弦的和环境污染物对植物的影响,必须按照植株的生长状况,发育阶段以及植株的不同部位,如根、茎、叶和果实或具体要求进行分别采样。为了植株同一部分进行比较分析,不能将植株的上、下部位随意混合。